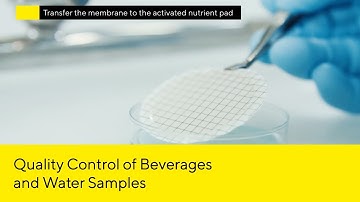
Nutrient Pad Sets for Quality Control of Beverages and Water Samples

⬇ DOWNLOAD NOW
Kalau muncul iklan pop-up, tutup lalu klik tombol kembali
Download lagu Quality Control of Microbiological Testing of Media secara gratis hanya untuk keperluan promosi. Dukung artis favorit kamu dengan membeli musik original di iTunes atau platform resmi lainnya.
 Quality Control of Microbiological Testing of Media. Last Part
Quality Control of Microbiological Testing of Media. Last Part
 Assuring Quality in Microbiology Diagnostics
Assuring Quality in Microbiology Diagnostics
 Sterility Testing performed at Nelson Labs
Sterility Testing performed at Nelson Labs
Nutrient Pad Sets for Quality Control of Beverages and Water Samples
Nutrient Pad Sets for Quality Control of Beverages and Water Samples
 Quality Control of Microbiological Testing of Media Part 03
Quality Control of Microbiological Testing of Media Part 03
 Microbiological Quality Control of Liquid Samples in Pharma-Compliant Industry
Microbiological Quality Control of Liquid Samples in Pharma-Compliant Industry
 Halal-Certified Culture Media for Microbial Testing
Halal-Certified Culture Media for Microbial Testing
 Microbial Identification | Vitek 2 Compact | Vitek MS
Microbial Identification | Vitek 2 Compact | Vitek MS